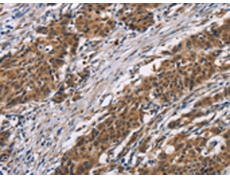
一抗

|
Background: |
Arylsulfatase B encoded by this gene belongs to the sulfatase family. The arylsulfatase B homodimer hydrolyzes sulfate groups of N-Acetyl-D-galactosamine, chondriotin sulfate, and dermatan sulfate. The protein is targetted to the lysozyme. Mucopolysaccharidosis type VI is an autosomal recessive lysosomal storage disorder resulting from a deficiency of arylsulfatase B. Two alternatively spliced transcript variants encoding distinct isoforms have been found for this gene. |
|
Applications: |
ELISA, WB, IHC |
|
Name of antibody: |
ARSB |
|
Immunogen: |
Synthetic peptide of human ARSB |
|
Full name: |
arylsulfatase B |
|
Synonyms: |
ASB; G4S; MPS6 |
|
SwissProt: |
P15848 |
|
IHC positive control: |
Human gastric cancer and human thyroid cancer |
|
IHC Recommend dilution: |
50-200 |
|
WB Predicted band size: |
60 kDa |
|
WB Positive control: |
Human fetal liver tissue |
|
WB Recommended dilution: |
200-1000 |


 購(gòu)物車(chē)
購(gòu)物車(chē) 幫助
幫助
 021-54845833/15800441009
021-54845833/15800441009